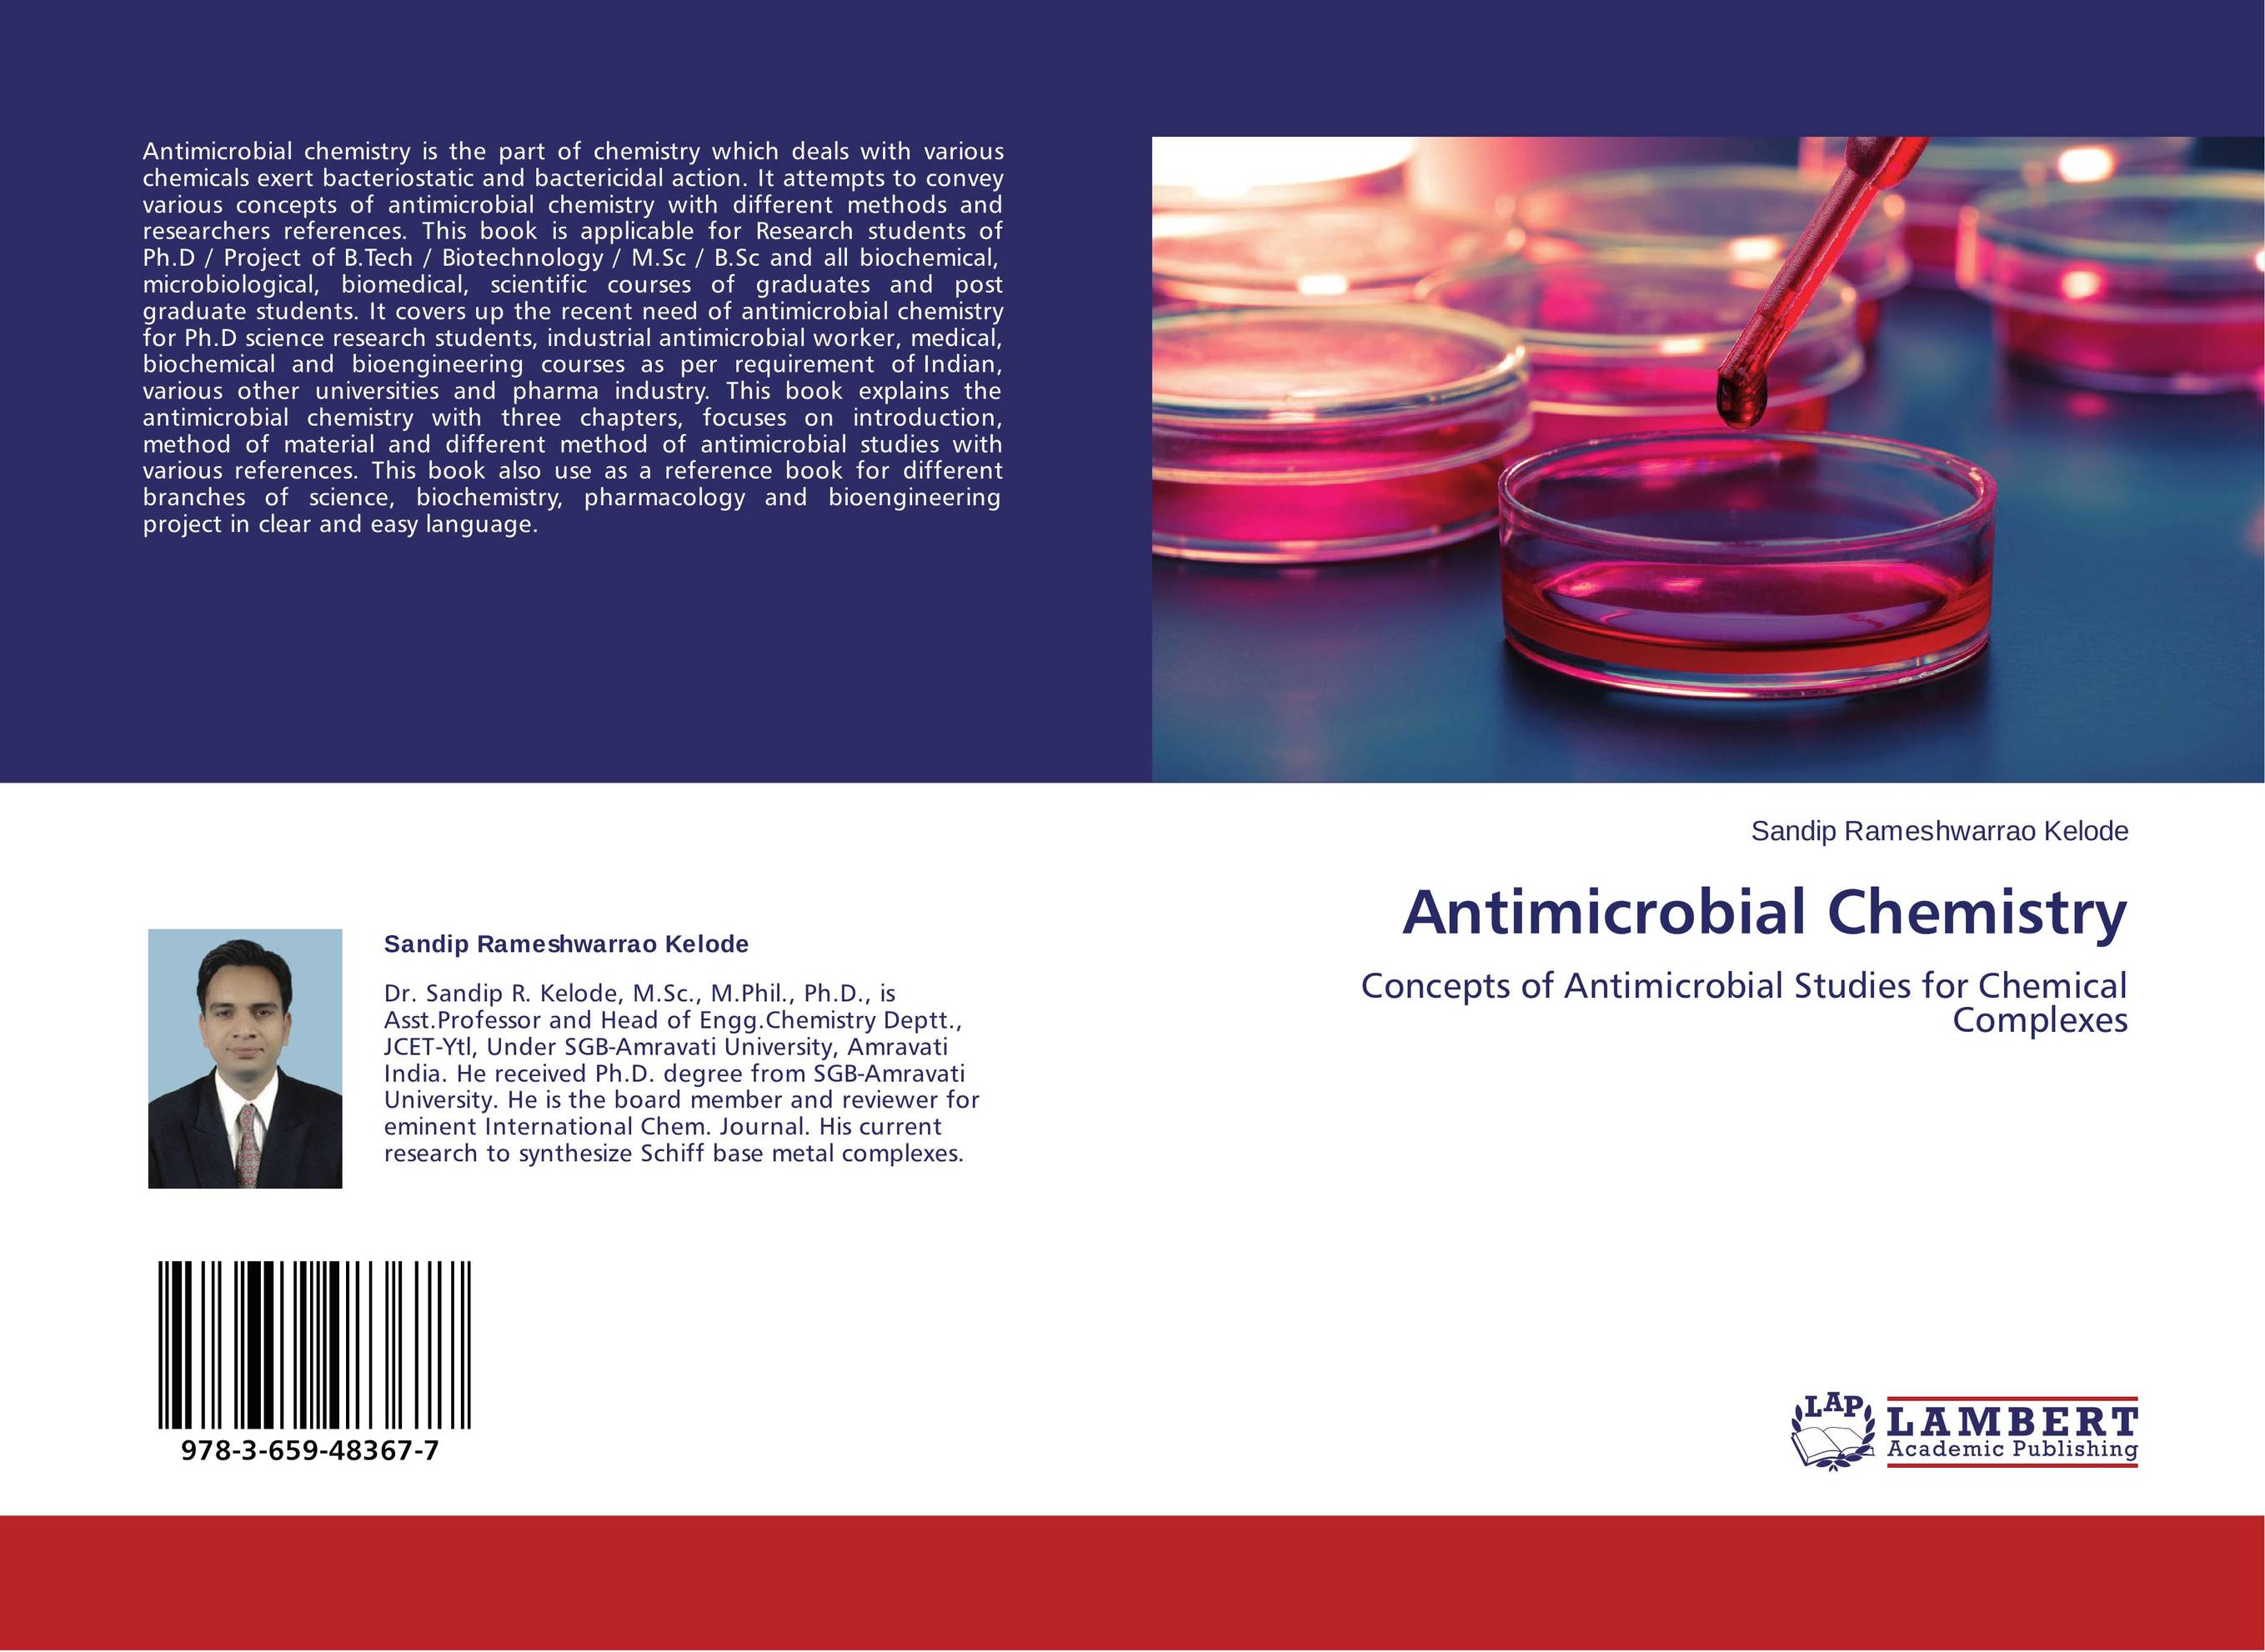
Antimicrobial Chemistry. Concepts of Antimicrobial Studies for Chemical Complexes.

📖 Antimicrobial Chemistry. Concepts of Antimicrobial Studies for Chemical Complexes.
Antimicrobial chemistry is the part of chemistry which deals with various chemicals exert bacteriostatic and bactericidal action. It attempts to convey various concepts of antimicrobial chemistry with different methods and researchers references. This book is applicable for Research students of Ph.D / Project of B.Tech / Biotechnology / M.Sc / B.Sc and all biochemical, microbiological, biomedical, scientific courses of graduates and post graduate students. It covers up the recent need of antimicrobial chemistry for Ph.D science research students, industrial antimicrobial worker, medical, biochemical and bioengineering courses as per requirement of Indian, various other universities and pharma industry. This book explains the antimicrobial chemistry with three chapters, focuses on introduction, method of material and different method of antimicrobial studies with various references. This book also use as a reference book for different branches of science, biochemistry, pharmacology and bioengineering project in clear and easy language.
О книге
автор, издательство, серия- Издательство
- LAP LAMBERT Academic Publishing
- ISBN
- 9783659483677
- Год
- 2013